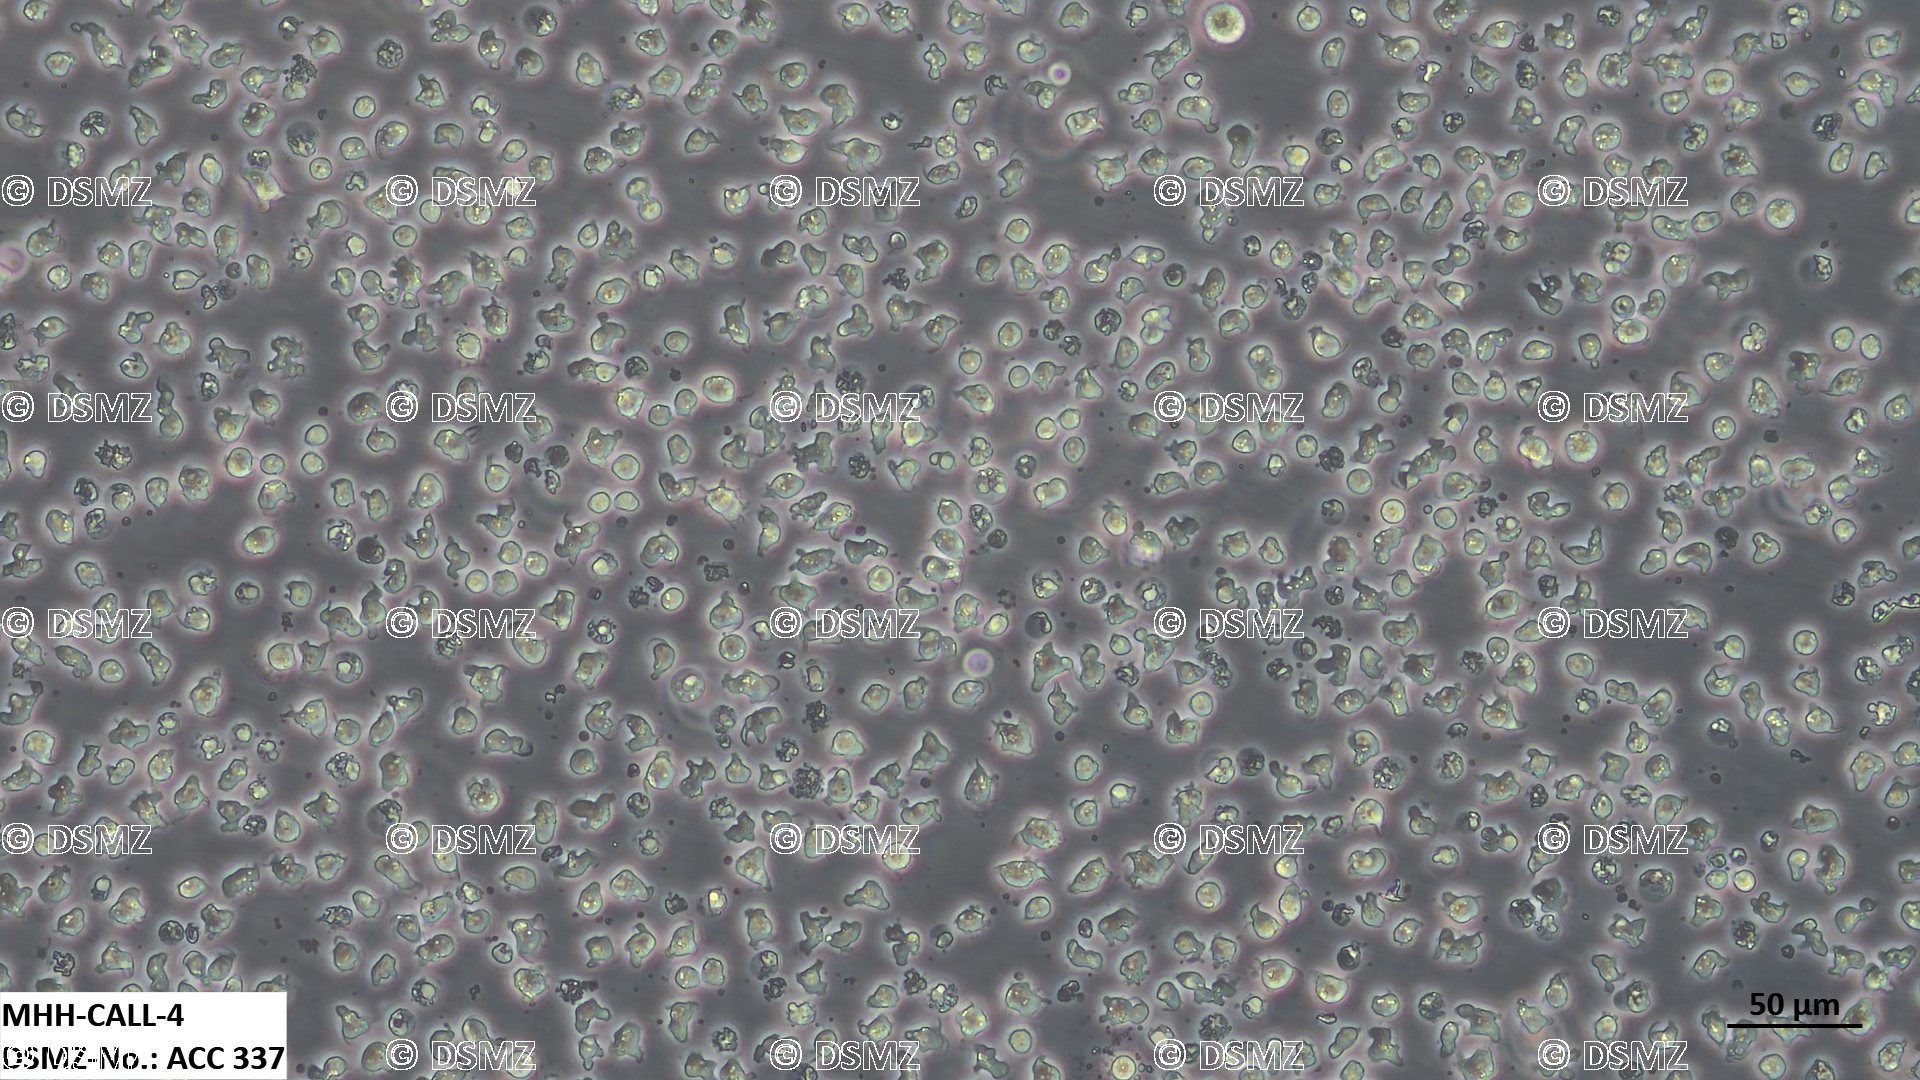

DSMZ(Deutsche Sammlung von Mikroorganismen und Zellkulturen)는 독일에 위치한
다양한 미생물 및 세포주를 보존하고 분배하는 세계적인 생물자원 센터입니다.

제품 설명
MHH-CALL-4
제품 번호
ACC 337
제품 특징
Species:
human (Homo sapiens)
Cell type:
B cell precursor leukemia
Origin:
established from the peripheral blood of a 10-year-old boy with acute lymphoblastic leukemia (pre B-ALL) at diagnosis in 1993
Permissions and restrictions:
Morphology:
single, small round cells growing in suspension, partly in clusters;
image;
imageMedium:
80% RPMI 1640 + 20% h.i. FBS
Subculture:
seed out at ca. 1 x 106 cells/ml (initially in a 24-well-plate is of advantage); optimal split ratio at about 1:2 once a week; culture should not be maintained <0.6 x 106 cells/ml
Incubation:
at 37 °C with 5% CO2
Doubling time:
ca. 80-100 hours
Harvest:
cell harvest of ca. 2 x 106 cells/ml
Storage:
frozen with 70% medium, 20% FBS, 10% DMSO
Mycoplasma:
negative in DAPI, microbiological culture, RNA hybridization, PCR assays
Immunology:
CD3 -, CD10 +, CD13 +, CD19 +, CD20 +, CD34 -, CD37 +, CD38 +, CD80 -, CD138 -, HLA-DR +, sm/cyIgG -, sm/cyIgM -, sm/cykappa -, sm/cylambda -;
imageAuthenticity:
STR analysis according to the global standard ANSI/ATCC ASN-0002.1-2021 (2021) resulted in an authentic STR profile of the reference STR database.
Cytogenetics:
human hypodiploid karyotype with 4% polyploidy - 45(42-46)<2n>X, -Y, r(12)(qter;p13-pter)
Viruses:
ELISA: reverse transcriptase negative; PCR: EBV -, HBV -, HCV -, HHV-8 -, HIV-1 -, HIV-2 -, HTLV-1/2 -, MLV -, SMRV -
Supplied as:
| Delivery form | | Prices |
|
| Frozen culture | | 450,- € |
Growing culture
(please inquire for exact delivery time) | | 900,- € |
| DNA isolated from cell line (25 µg) | | 560,- € |
| DNA isolated from cell line (5 µg) | | 140,- € |
see price list
DSMZ의 모든 제품들을 만나보세요!
DSMZ - Official Distributor in South Korea "Morebio" 한국 공식 대리점 "모아바이오"